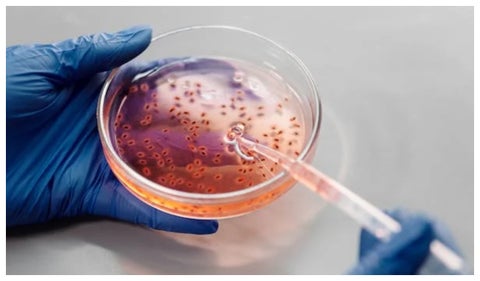

Últimas noticias sobre superbacterias
Noticias
Adultos mayores
Alerta por nuevo pico respiratorio que está afectando no solo a niños, sino a adultos mayores
Según los especialistas, se han registrado más de 87.000 consultas en lo que va del año.

Contenido patrocinado
FAO impulsa estrategias para la contención de la Resistencia a los Antimicrobianos en el sector agropecuario

Últimas Noticias
Desplazamiento forzado
Enfrentamientos entre grupos ilegales dejan más de 100 desplazados en Linares, Nariño.
Habitantes del sector aseguran que estos grupos han venido asentándose en la región desde hace aproximadamente dos años y medio.

Perú
Elecciones presidenciales en Perú 2026: tres claves para entender la segunda vuelta entre Fujimori y Sánchez

"Reconozca los resultados": la respuesta de De la Espriella a las exigencias de Cepeda para el debate
Abelardo de la Espriella reaccionó a las condiciones planteadas por Iván Cepeda para avanzar en la organización del debate presidencial de segunda vuelta.
Lista de trabajadores que tendrán nuevo aumento salarial en julio 2026
El incremento del recargo dominical y festivo beneficiará a miles de empleados en Colombia con una remuneración más alta.
“El régimen sigue intacto”: experto ve imposible que haya elecciones en Venezuela a corto plazo

“El modus operandi es muy parecido”: coincidencias entre el caso de Kevin Santiago Ángel y otras muertes bajo investigación

Así funcionaría el cambio de hora en Colombia que proponen para evitar apagones por el fenómeno de El Niño

Colombia clasifica a la Copa del mundo de Brasil 2027 tras vencer a Uruguay

Miguel Uribe Turbay: un año del atentado que estremeció al país

'Si tienen condiciones de hambre puede influir en el canibalismo': doctor en biología cuestiona condiciones del caimán llanero

Jota Pe Hernández no ha podido separarse del Partido Verde: su única salida es que lo expulsen

Las campañas tendrán la posibilidad de tener dos testigos por cada mesa en el país: El CNE sobre segunda vuelta

'Hablé con Gustavo Petro porque él me llamó y es el presidente': detalles de los movimientos de Juan Daniel Oviedo a segunda vuelta

"El 7 de agosto se acaba la falsa paz total": el mensaje de Mauricio Gómez Amín para sumar votos del centro a Abelardo de la Espriella